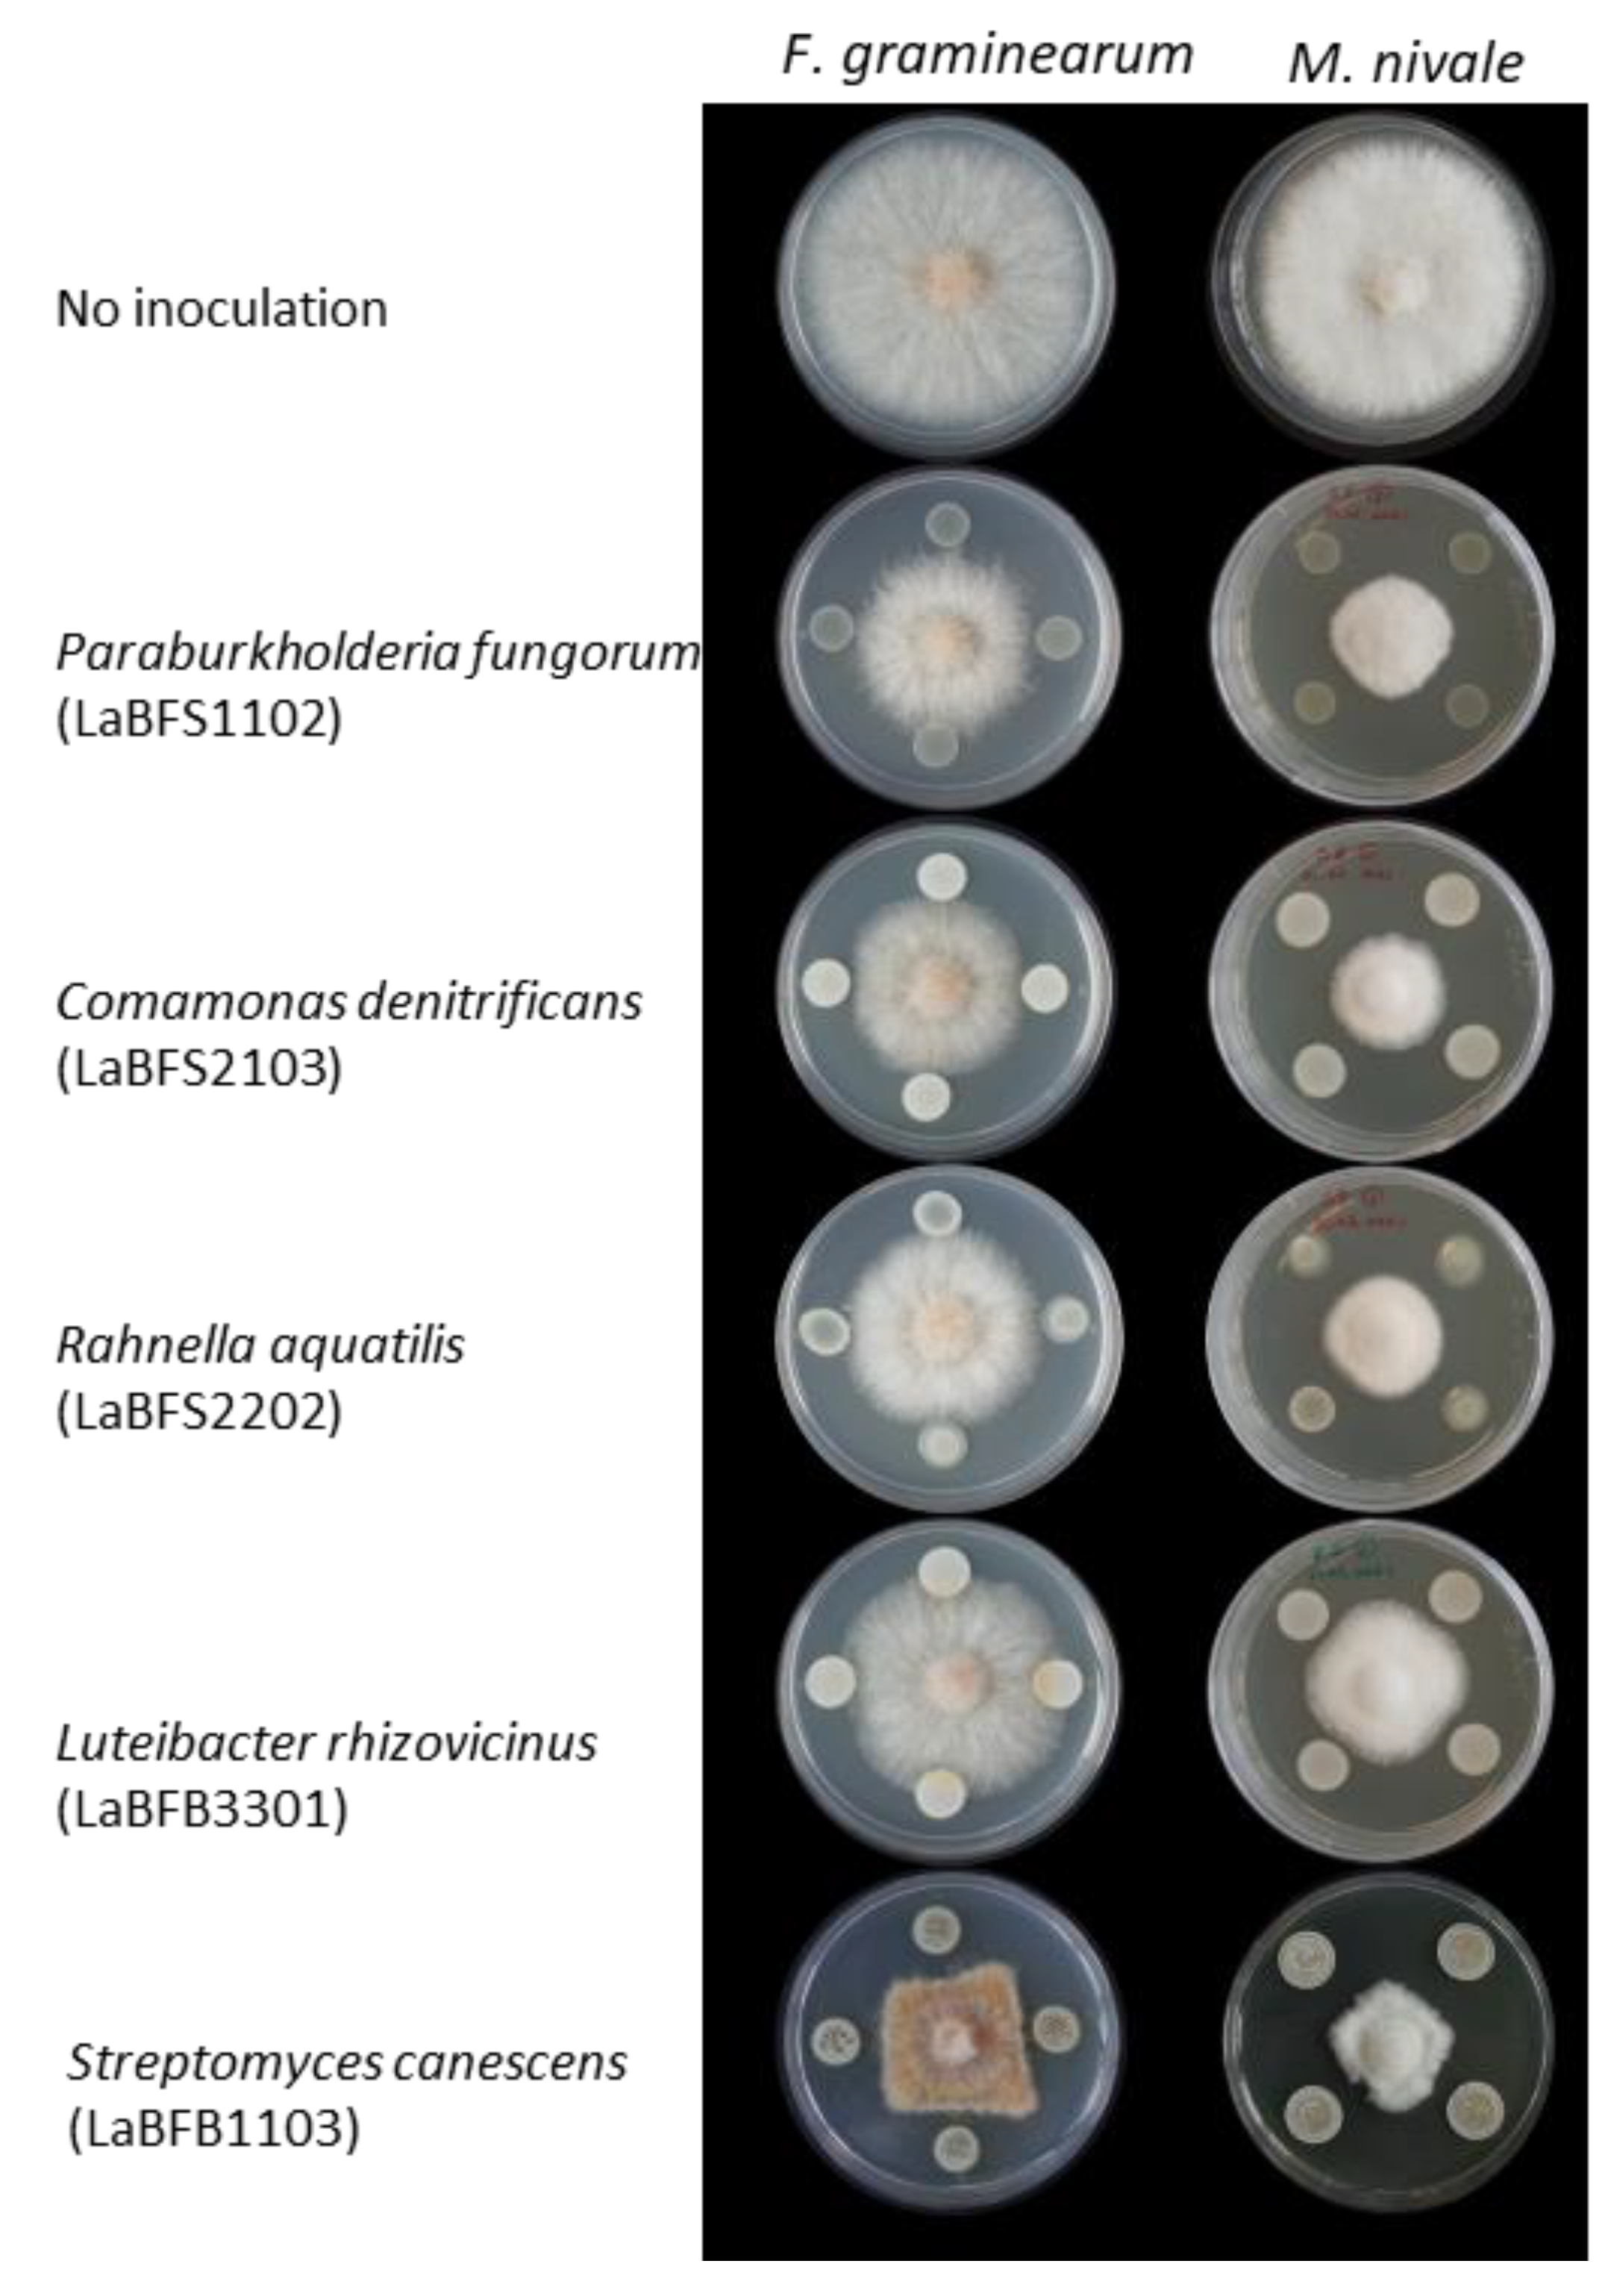
Microorganisms 10 02089 g006

Screening of Endophytic Bacteria of Leucojum aestivum ‘Gravety Giant’ as a Potential Source of Alkaloids and as Antagonist to Some Plant Fungal Pathogens
Abstract
1. Introduction
2. Materials and Methods
2.1. Plant Material and Culture Conditions
2.2. Bacterial Isolation and Cultivation
2.3. Molecular Identification
2.4. Crude Extract Preparation of Bacterial Pellet
2.5. High-Performance Thin-Layer Chromatography (HPTLC) Analysis and Alkaloid Detection with Dragendorff’s Reagent
2.6. Dual-Culture Assay to Test the Antagonistic Activity of Endophytic Bacteria against Two Cereal Pathogens
2.7. Diffusion Assay of Cell-Free Culture Broth and Methanolic Extracts of the Selected Strains against F. graminearum mycelia
2.8. LC-MS Equipment and Analysis
2.9. Data Analysis
3. Results
3.1. Bacterial Collection Isolated from L. aestivum ‘Gravety Giant’
3.2. Analysis of the Composition of Cultivable Endophytic Bacteria from L. aestivum ‘Gravety Giant’
3.3. Alkaloid Screening Using High-Performance Thin-Layer Chromatography (HPTLC) Analysis
3.4. Antifungal Activities of the Isolates
3.5. Antagonism Activities of Cell-Free Supernatant and Methanolic Extracts against F. graminearum
3.6. Untargeted LC-MS/MS Analysis
4. Discussion
5. Conclusions
Supplementary Materials
Author Contributions
Funding
Acknowledgments
Conflicts of Interest
References
- Strobel, G.A. Endophytes as Sources of Bioactive Products. Microbes Infect. 2003, 5, 535–544. [Google Scholar] [CrossRef]
- Durán, P.; Thiergart, T.; Garrido-Oter, R.; Agler, M.; Kemen, E.; Schulze-Lefert, P.; Hacquard, S. Microbial Interkingdom Interactions in Roots Promote Arabidopsis Survival. Cell 2018, 175, 973–983.e14. [Google Scholar] [CrossRef] [PubMed]
- Brader, G.; Compant, S.; Mitter, B.; Trognitz, F.; Sessitsch, A. Metabolic Potential of Endophytic Bacteria. Curr. Opin. Biotechnol. 2014, 27, 30–37. [Google Scholar] [CrossRef] [PubMed]
- Rosenblueth, M.; Martínez-Romero, E. Bacterial Endophytes and Their Interactions with Hosts. Mol. Plant-Microbe Interact. 2006, 19, 827–837. [Google Scholar] [CrossRef] [PubMed]
- Bulgarelli, D.; Rott, M.; Schlaeppi, K.; van Themaat, E.V.L.; Ahmadinejad, N.; Assenza, F.; Rauf, P.; Huettel, B.; Reinhardt, R.; Schmelzer, E.; et al. Revealing Structure and Assembly Cues for Arabidopsis Root-Inhabiting Bacterial Microbiota. Nature 2012, 488, 91–95. [Google Scholar] [CrossRef] [PubMed]
- Lundberg, D.S.; Lebeis, S.L.; Paredes, S.H.; Yourstone, S.; Gehring, J.; Malfatti, S.; Tremblay, J.; Engelbrektson, A.; Kunin, V.; del Rio, T.G.; et al. Defining the Core Arabidopsis Thaliana Root Microbiome. Nature 2012, 488, 86–90. [Google Scholar] [CrossRef] [PubMed]
- Sturz, A.V.; Christie, B.R.; Nowak, J. Bacterial Endophytes: Potential Role in Developing Sustainable Systems of Crop Production. Crit. Rev. Plant Sci. 2000, 19, 1–30. [Google Scholar] [CrossRef]
- Bulgarelli, D.; Schlaeppi, K.; Spaepen, S.; van Themaat, E.V.L.; Schulze-Lefert, P. Structure and Functions of the Bacterial Microbiota of Plants. Annu. Rev. Plant Biol. 2013, 64, 807–838. [Google Scholar] [CrossRef]
- Sturz, A.V.; Christie, B.R.; Matheson, B.G.; Nowak, J. Biodiversity of Endophytic Bacteria Which Colonize Red Clover Nodules, Roots, Stems and Foliage and Their Influence on Host Growth. Biol. Fertil. Soils 1997, 25, 13–19. [Google Scholar] [CrossRef]
- Igarashi, Y. Screening of Novel Bioactive Compounds from Plant-Associated Actinomycetes. Actinomycetologica 2004, 18, 63–66. [Google Scholar] [CrossRef]
- Castillo, U.; Harper, J.K.; Strobel, G.A.; Sears, J.; Alesi, K.; Ford, E.; Lin, J.; Hunter, M.; Maranta, M.; Ge, H.; et al. Kakadumycins, Novel Antibiotics from Streptomyces Sp NRRL 30566, an Endophyte of Grevillea Pteridifolia. FEMS Microbiol. Lett. 2003, 224, 183–190. [Google Scholar] [CrossRef]
- Khiralla, A.; Spina, R.; Saliba, S.; Laurain-Mattar, D. Diversity of Natural Products of the Genera Curvularia and Bipolaris. Fungal Biol. Rev. 2019, 33, 101–122. [Google Scholar] [CrossRef]
- Jia, M.; Chen, L.; Xin, H.-L.; Zheng, C.-J.; Rahman, K.; Han, T.; Qin, L.-P. A Friendly Relationship between Endophytic Fungi and Medicinal Plants: A Systematic Review. Front. Microbiol. 2016, 7, 906. [Google Scholar] [CrossRef] [PubMed]
- Soujanya, K.N.; Siva, R.; Mohana Kumara, P.; Srimany, A.; Ravikanth, G.; Mulani, F.A.; Aarthy, T.; Thulasiram, H.V.; Santhoshkumar, T.R.; Nataraja, K.N.; et al. Camptothecin-Producing Endophytic Bacteria from Pyrenacantha Volubilis Hook. (Icacinaceae): A Possible Role of a Plasmid in the Production of Camptothecin. Phytomedicine 2017, 36, 160–167. [Google Scholar] [CrossRef]
- Alvin, A.; Miller, K.I.; Neilan, B.A. Exploring the Potential of Endophytes from Medicinal Plants as Sources of Antimycobacterial Compounds. Microbiol. Res. 2014, 169, 483–495. [Google Scholar] [CrossRef]
- Wu, W.; Chen, W.; Liu, S.; Wu, J.; Zhu, Y.; Qin, L.; Zhu, B. Beneficial Relationships Between Endophytic Bacteria and Medicinal Plants. Front. Plant Sci. 2021, 12, 646146. [Google Scholar] [CrossRef]
- Inahashi, Y.; Iwatsuki, M.; Ishiyama, A.; Matsumoto, A.; Hirose, T.; Oshita, J.; Sunazuka, T.; Panbangred, W.; Takahashi, Y.; Kaiser, M.; et al. Actinoallolides A-E, New Anti-Trypanosomal Macrolides, Produced by an Endophytic Actinomycete, Actinoallomurus Fulvus MK10-036. Org. Lett. 2015, 17, 864–867. [Google Scholar] [CrossRef]
- Miller, C.M.; Miller, R.V.; Garton-Kenny, D.; Redgrave, B.; Sears, J.; Condron, M.M.; Teplow, D.B.; Strobel, G.A. Ecomycins, Unique Antimycotics from Pseudomonas Viridiflava. J. Appl. Microbiol. 1998, 84, 937–944. [Google Scholar] [CrossRef]
- Kusari, S.; Lamshöft, M.; Kusari, P.; Gottfried, S.; Zühlke, S.; Louven, K.; Hentschel, U.; Kayser, O.; Spiteller, M. Endophytes Are Hidden Producers of Maytansine in Putterlickia Roots. J. Nat. Prod. 2014, 77, 2577–2584. [Google Scholar] [CrossRef]
- Shweta, S.; Bindu, J.H.; Raghu, J.; Suma, H.K.; Manjunatha, B.L.; Kumara, P.M.; Ravikanth, G.; Nataraja, K.N.; Ganeshaiah, K.N.; Uma Shaanker, R. Isolation of Endophytic Bacteria Producing the Anti-Cancer Alkaloid Camptothecine from Miquelia Dentata Bedd. (Icacinaceae). Phytomedicine 2013, 20, 913–917. [Google Scholar] [CrossRef]
- Chung, B.-S.; Aslam, Z.; Kim, S.-W.; Kim, G.-G.; Kang, H.-S.; Ahn, J.-W.; Chung, Y. A Bacterial Endophyte, Pseudomonas Brassicacearum YC5480, Isolated from the Root of Artemisia Sp. Producing Antifungal and Phytotoxic Compounds. Plant Pathol. J. 2008, 24, 461–468. [Google Scholar] [CrossRef]
- Agisha, V.N.; Kumar, A.; Eapen, S.J.; Sheoran, N.; Suseelabhai, R. Broad-Spectrum Antimicrobial Activity of Volatile Organic Compounds from Endophytic Pseudomonas Putida BP25 against Diverse Plant Pathogens. Biocontrol Sci. Technol. 2019, 29, 1069–1089. [Google Scholar] [CrossRef]
- Sheoran, N.; Valiya Nadakkakath, A.; Munjal, V.; Kundu, A.; Subaharan, K.; Venugopal, V.; Rajamma, S.; Eapen, S.J.; Kumar, A. Genetic Analysis of Plant Endophytic Pseudomonas Putida BP25 and Chemo-Profiling of Its Antimicrobial Volatile Organic Compounds. Microbiol. Res. 2015, 173, 66–78. [Google Scholar] [CrossRef]
- Jin, Z.; Yao, G. Amaryllidaceae and Sceletium Alkaloids. Nat. Prod. Rep. 2019, 36, 1462–1488. [Google Scholar] [CrossRef]
- Wang, W.-X.; Kusari, S.; Sezgin, S.; Lamshöft, M.; Kusari, P.; Kayser, O.; Spiteller, M. Hexacyclopeptides Secreted by an Endophytic Fungus Fusarium Solani N06 Act as Crosstalk Molecules in Narcissus Tazetta. Appl. Microbiol. Biotechnol. 2015, 99, 7651–7662. [Google Scholar] [CrossRef]
- Spina, R.; Saliba, S.; Dupire, F.; Ptak, A.; Hehn, A.; Piutti, S.; Poinsignon, S.; Leclerc, S.; Bouguet-Bonnet, S.; Laurain-Mattar, D. Molecular Identification of Endophytic Bacteria in Leucojum aestivum In Vitro Culture, NMR-Based Metabolomics Study and LC-MS Analysis Leading to Potential Amaryllidaceae Alkaloid Production. Int. J. Mol. Sci. 2021, 22, 1773. [Google Scholar] [CrossRef]
- Berkov, S.; Georgieva, L.; Kondakova, V.; Atanassov, A.; Viladomat, F.; Bastida, J.; Codina, C. Plant Sources of Galanthamine: Phytochemical and Biotechnological Aspects. Biotechnol. Biotechnol. Equip. 2009, 23, 1170–1176. [Google Scholar] [CrossRef]
- Munakata, Y.; Gavira, C.; Genestier, J.; Bourgaud, F.; Hehn, A.; Slezack-Deschaumes, S. Composition and Functional Comparison of Vetiver Root Endophytic Microbiota Originating from Different Geographic Locations That Show Antagonistic Activity towards Fusarium Graminearum. Microbiol. Res. 2021, 243, 126650. [Google Scholar] [CrossRef]
- Palmieri, A.; Petrini, M. Tryptophol and Derivatives: Natural Occurrence and Applications to the Synthesis of Bioactive Compounds. Nat. Prod. Rep. 2019, 36, 490–530. [Google Scholar] [CrossRef] [PubMed]
- Rebotiloe, F.M.; Eunice, U.-J.; Mahloro, H.S.-D. Isolation and Identification of Bacterial Endophytes from Crinum Macowanii Baker. Afr. J. Biotechnol. 2018, 17, 1040–1047. [Google Scholar] [CrossRef]
- Sebola, T.E.; Uche-Okereafor, N.C.; Tapfuma, K.I.; Mekuto, L.; Green, E.; Mavumengwana, V. Evaluating Antibacterial and Anticancer Activity of Crude Extracts of Bacterial Endophytes from Crinum Macowanii Baker Bulbs. Microbiologyopen 2019, 8, e914. [Google Scholar] [CrossRef] [PubMed]
- Sebola, T.E.; Uche-Okereafor, N.C.; Mekuto, L.; Makatini, M.M.; Green, E.; Mavumengwana, V. Antibacterial and Anticancer Activity and Untargeted Secondary Metabolite Profiling of Crude Bacterial Endophyte Extracts from Crinum Macowanii Baker Leaves. Int. J. Microbiol. 2020, 2020, 8839490. [Google Scholar] [CrossRef] [PubMed]
- Liu, Z.; Zhou, J.; Li, Y.; Wen, J.; Wang, R. Bacterial Endophytes from Lycoris Radiata Promote the Accumulation of Amaryllidaceae Alkaloids. Microbiol. Res. 2020, 239, 126501. [Google Scholar] [CrossRef]
- Diop, M.F.; Hehn, A.; Ptak, A.; Chrétien, F.; Doerper, S.; Gontier, E.; Bourgaud, F.; Henry, M.; Chapleur, Y.; Laurain-Mattar, D. Hairy Root and Tissue Cultures of Leucojum aestivum L.—Relationships to Galanthamine Content. Phytochem. Rev. 2007, 6, 137–141. [Google Scholar] [CrossRef]
- Afzal, I.; Shinwari, Z.K.; Sikandar, S.; Shahzad, S. Plant Beneficial Endophytic Bacteria: Mechanisms, Diversity, Host Range and Genetic Determinants. Microbiol. Res. 2019, 221, 36–49. [Google Scholar] [CrossRef]
- Correa-Galeote, D.; Bedmar, E.J.; Arone, G.J. Maize Endophytic Bacterial Diversity as Affected by Soil Cultivation History. Front. Microbiol. 2018, 9, 484. [Google Scholar] [CrossRef] [PubMed]
- Okunishi, S.; Sako, K.; Mano, H.; Imamura, A.; Morisaki, H. Bacterial Flora of Endophytes in the Maturing Seed of Cultivated Rice (Oryza Sativa). Microbes Environ. 2005, 20, 168–177. [Google Scholar] [CrossRef]
- Guo, J.; Ling, N.; Li, Y.; Li, K.; Ning, H.; Shen, Q.; Guo, S.; Vandenkoornhuyse, P. Seed-Borne, Endospheric and Rhizospheric Core Microbiota as Predictors of Plant Functional Traits across Rice Cultivars Are Dominated by Deterministic Processes. New Phytol. 2021, 230, 2047–2060. [Google Scholar] [CrossRef]
- Ryan, R.P.; Germaine, K.; Franks, A.; Ryan, D.J.; Dowling, D.N. Bacterial Endophytes: Recent Developments and Applications. FEMS Microbiol. Lett. 2008, 278, 1–9. [Google Scholar] [CrossRef]
- Ek-Ramos, M.J.; Gomez-Flores, R.; Orozco-Flores, A.A.; Rodríguez-Padilla, C.; González-Ochoa, G.; Tamez-Guerra, P. Bioactive Products From Plant-Endophytic Gram-Positive Bacteria. Front. Microbiol. 2019, 10, 463. [Google Scholar] [CrossRef] [PubMed]
- Anandan, K.; Vittal, R.R. Endophytic Paenibacillus Amylolyticus KMCLE06 Extracted Dipicolinic Acid as Antibacterial Agent Derived via Dipicolinic Acid Synthetase Gene. Curr. Microbiol. 2019, 76, 178–186. [Google Scholar] [CrossRef]
- Khan, M.M.A.; Haque, E.; Paul, N.C.; Khaleque, M.A.; Al-Garni, S.M.S.; Rahman, M.; Islam, M.T. Enhancement of Growth and Grain Yield of Rice in Nutrient Deficient Soils by Rice Probiotic Bacteria. Rice Sci. 2017, 24, 264–273. [Google Scholar] [CrossRef]
- Rahman, M.; Sabir, A.A.; Mukta, J.A.; Khan, M.M.A.; Mohi-Ud-Din, M.; Miah, M.G.; Rahman, M.; Islam, M.T. Plant Probiotic Bacteria Bacillus and Paraburkholderia Improve Growth, Yield and Content of Antioxidants in Strawberry Fruit. Sci. Rep. 2018, 8, 2504. [Google Scholar] [CrossRef]
- Marasco, R.; Rolli, E.; Fusi, M.; Cherif, A.; Abou-Hadid, A.; El-Bahairy, U.; Borin, S.; Sorlini, C.; Daffonchio, D. Plant Growth Promotion Potential Is Equally Represented in Diverse Grapevine Root-Associated Bacterial Communities from Different Biopedoclimatic Environments. Biomed Res. Int. 2013, 2013, 491091. [Google Scholar] [CrossRef]
- Asselin, J.E.; Eikemo, H.; Perminow, J.; Nordskog, B.; Brurberg, M.B.; Beer, S.V. Rahnella Spp. Are Commonly Isolated from Onion (Allium Cepa) Bulbs and Are Weakly Pathogenic. J. Appl. Microbiol. 2019, 127, 812–824. [Google Scholar] [CrossRef]
- Guglielmetti, S.; Basilico, R.; Taverniti, V.; Arioli, S.; Piagnani, C.; Bernacchi, A. Luteibacter Rhizovicinus MIMR1 Promotes Root Development in Barley (Hordeum Vulgare L.) under Laboratory Conditions. World J. Microbiol. Biotechnol. 2013, 29, 2025–2032. [Google Scholar] [CrossRef] [PubMed]
- Sun, S.-L.; Yang, W.-L.; Fang, W.-W.; Zhao, Y.-X.; Guo, L.; Dai, Y.-J. The Plant Growth-Promoting Rhizobacterium Variovorax Boronicumulans CGMCC 4969 Regulates the Level of Indole-3-Acetic Acid Synthesized from Indole-3-Acetonitrile. Appl. Environ. Microbiol. 2018, 84, e00298-18. [Google Scholar] [CrossRef]
- Esmaeel, Q.; Miotto, L.; Rondeau, M.; Leclère, V.; Clément, C.; Jacquard, C.; Sanchez, L.; Barka, E.A. Paraburkholderia Phytofirmans PsJN-Plants Interaction: From Perception to the Induced Mechanisms. Front. Microbiol. 2018, 9, 2093. [Google Scholar] [CrossRef] [PubMed]
- Singkum, P.; Muangkaew, W.; Suwanmanee, S.; Pumeesat, P.; Wongsuk, T.; Luplertlop, N. Suppression of the Pathogenicity of Candida Albicans by the Quorum-Sensing Molecules Farnesol and Tryptophol. J. Gen. Appl. Microbiol. 2020, 65, 277–283. [Google Scholar] [CrossRef]
- Nishanth Kumar, S.; Mohandas, C.; Nambisan, B. Purification, Structural Elucidation and Bioactivity of Tryptophan Containing Diketopiperazines, from Comamonas Testosteroni Associated with a Rhabditid Entomopathogenic Nematode against Major Human-Pathogenic Bacteria. Peptides 2014, 53, 48–58. [Google Scholar] [CrossRef] [PubMed]

| Source Tissues | Strain | GenBank Accession | Blast Top Hit | E Value | Inhibition Rate vs. Fg (Mean +/− SE) | Inhibition Rate vs. Mn (Mean +/− SE) | Dragendorff |
|---|---|---|---|---|---|---|---|
| Shoot | LaBFS1102 | OL307020 | Paraburkholderia fungorum strain LMG 16225 | 0 | 41.91 ± 0.19 | 56.69 ± 0.12 | Yes |
| LaBFS1106 | OL307021 | Patulibacter ginsengiterrae strain P4–5 | 0 | - | - | Yes | |
| LaBFS1107 | OL307022 | Chitinophaga ginsengisegetis strain Gsoil 040 | 0 | 26.57 ± 0.67 | 14.54 ± 2.3 | Yes | |
| LaBFS1112 | OL307023 | Variovorax ginsengisoli strain Gsoil 3165 | 0 | 0 ± 0.2 | 9.15 ± 0.76 | Yes | |
| LaBFS1201 | OL307024 | Staphylococcus warneri strain AW 25 | 0 | 37.71 ± 0.57 | 29.73 ± 3.06 | Yes | |
| LaBFS1208 | Mycolicibacterium setense strain CIP 109395 | 1 × 10−151 | 2.81 ± 0.74 | 8.87 ± 0.82 | Yes | ||
| LaBFS1307 | OL307027 | Microbacterium luteolum strain IFO 15074 | 0 | 4.79 ± 0.95 | 4.17 ± 1.21 | Yes | |
| LaBFS2103 | OL307031 | Comamonas denitrificans strain 123 | 0 | 43.51 ± 0.09 | 58.82 ± 1.19 | Yes | |
| LaBFS2201 | Microbacterium arthrosphaerae strain CC-VM-Y | 7 × 10−55 | −0.8 ± 0.06 | 6.17 ± 0.16 | Yes | ||
| LaBFS3105 | OL307062 | Variovorax paradoxus strain NBRC 15149 | 0 | 3.4 ± 0.23 | 7.54 ± 2.97 | Yes | |
| LaBFS3313 | OL307078 | Arthrobacter oryzae strain KV-651 | 0 | 30.73 ± 0.96 | 18.46 ± 3.11 | Not performed | |
| Bulb | LaBFB1102 | OL307013 | Paenibacillus amylolyticus strain JCM 9906 | 0 | −0.4 ± 0.12 | 0 ± 0 | Yes |
| LaBFB1103 | OL307014 | Streptomyces canescens strain DSM 40001 | 0 | 49.59 ± 0.79 | 59.85 ± 0.82 | Not performed | |
| LaBFB1301 | OL307015 | Patulibacter ginsengiterrae strain P4–5 | 0 | 2.99 ± 1.04 | 32.61 ± 0.36 | Yes | |
| LaBFB1302 | OL307016 | Patulibacter ginsengiterrae strain P4–5 | 0 | 1.6 ± 0.35 | 32.62 ± 0.91 | Yes | |
| LaBFB3301 | OL307019 | Luteibacter rhizovicinus strain LJ96 | 0 | 37.32 ± 0.2 | 48.06 ± 1.01 | Yes |
| Enrichment in the Samples (Compared with Medium Control) | Compound Name | Formula | Molecular Weight | Error (ppm) | RT (Min) |
|---|---|---|---|---|---|
| LaBFB3301 unique | N2,1-Diphenyl-6-imino-1,6-dihydro-1,3,5-triazine-2,4-diamine | C15H14N6 | 278.12676 | 7.16 | |
| O-Arachidonoyl ethanolamine | C22H37NO2 | 347.28231 | 0.34 | 33.43 | |
| L(-)-Carnitine | C7H15NO3 | 161.10521 | 0.10 | 1.64 | |
| Adenine | C5H5N5 | 135.05452 | 0.18 | 1.84 | |
| 2′-O-Methyladenosine | C11H15N5O4 | 281.11252 | 0.41 | 3.11 | |
| Betulin | C30H50O2 | 442.38107 | 0.02 | 35.83 | |
| R-Palmitoyl-(2-methyl) ethanolamide | C19H39NO2 | 313.29806 | 27.45 | ||
| LaBFS1102 unique | 16-Heptadecyne-1,2,4-triol | C17H32O3 | 284.23524 | 0.33 | 32.86 |
| Ethyl oleate | C20H38O2 | 310.28724 | 0.19 | 38.96 | |
| Palmitelaidic acid methyl ester | C17H32O2 | 268.2403 | 34.74 | ||
| Guanine | C5H5N5O | 151.04933 | 0.53 | 2.66 | |
| Ethyl palmitoleate | C18H34O2 | 282.25602 | 0.49 | 35.39 | |
| cis-12-Octadecenoic acid methyl ester | C19H36O2 | 296.27171 | 0.61 | 36.45 | |
| 3-amino-2-phenyl-2H-pyrazolo [4,3-c]pyridine-4,6-diol | C12H10N4O2 | 242.0804 | 0.10 | 16.44 | |
| 1,4:3,6-Dianhydro-2-(benzoylamino)-2,5-dideoxy-5-{[4-(3-fluorophenyl)-2-pyrimidinyl]amino}-L-iditol | C23H21FN4O3 | 420.15888 | 30.35 | ||
| Shared peaks between LaBFB3301 and LaBFS1203 | 6,7-dihydro-5H-dibenzo[d,f][1,3]diazepin-6-one | C13H10N2O | 210.07936 | 20.64 | |
| Shared peaks between LaBFB3301 and LaBFS2103 | L-Histidine | C6H9N3O2 | 155.06942 | 0.52 | 1.52 |
| S-Adenosylhomocysteine | C14H20N6O5S | 384.12149 | 0.26 | 1.85 | |
| Linoleoyl Ethanolamide | C20H37NO2 | 323.28237 | 1.14 | 32.46 | |
| Propionylcarnitine | C10H19NO4 | 217.1315 | 0.42 | 1.97 | |
| Stearoyl ethanolamide | C20H41NO2 | 327.31365 | 0.24 | 34.99 | |
| N6-Acetyl-L-lysine | C8H16N2O3 | 188.11604 | 0.32 | 1.80 | |
| 3-(2-Hydroxyethyl)indole | C10H11NO | 161.08402 | 0.50 | 13.90 | |
| 9(Z),11(E),13(E)-Octadecatrienoic Acid methyl ester | C19H32O2 | 292.24043 | 0.68 | 35.25 | |
| Cytidine 5′-diphosphocholine | C14H26N4O11P2 | 488.10714 | 0.33 | 1.83 | |
| Hypoxanthine | C5H4N4O | 136.03845 | 0.45 | 2.10 | |
| L-Glutathione oxidized | C20H32N6O12S2 | 612.15152 | 0.72 | 195 | |
| Imidazolelactic acid | C6H8N2O3 | 156.05344 | 0.33 | 1.81 | |
| UDP-N-acetylglucosamine | C17H27N3O17P2 | 607.08158 | 0.31 | 2.40 | |
| 11(Z),14(Z),17(Z)-Eicosatrienoic acid | C20H34O2 | 306.25594 | 0.19 | 35.05 | |
| Υ-Glutamylcysteine | C8H14N2O5S | 250.06235 | 0.03 | 2.01 | |
| Biotin | C10H16N2O3S | 244.0882 | 0.15 | 10.72 | |
| Ergosterol peroxide | C28H44O3 | 428.32901 | 0.08 | 34.95 | |
| Shared peaks among the three strains | Adenosine 5′-monophosphate | C10H14N5O7P | 347.06301 | 0.22 | 1.88 |
| Palmitoyl ethanolamide | C18H37NO2 | 299.28252 | 0.30 | 33.11 | |
| Oleoyl ethanolamide | C20H39NO2 | 325.29805 | 0.05 | 33.69 | |
| Nicotinamide adenine dinucleotide (NAD+) | C21H27N7O14P2 | 663.10893 | 0.29 | 1.86 | |
| Azobenzene | C12H10N2 | 182.08434 | 0.32 | 10.46 |
Publisher’s Note: MDPI stays neutral with regard to jurisdictional claims in published maps and institutional affiliations. |
© 2022 by the authors. Licensee MDPI, Basel, Switzerland. This article is an open access article distributed under the terms and conditions of the Creative Commons Attribution (CC BY) license (https://creativecommons.org/licenses/by/4.0/).
Share and Cite
Munakata, Y.; Spina, R.; Slezack-Deschaumes, S.; Genestier, J.; Hehn, A.; Laurain-Mattar, D. Screening of Endophytic Bacteria of Leucojum aestivum ‘Gravety Giant’ as a Potential Source of Alkaloids and as Antagonist to Some Plant Fungal Pathogens. Microorganisms 2022, 10, 2089. https://doi.org/10.3390/microorganisms10102089
Munakata Y, Spina R, Slezack-Deschaumes S, Genestier J, Hehn A, Laurain-Mattar D. Screening of Endophytic Bacteria of Leucojum aestivum ‘Gravety Giant’ as a Potential Source of Alkaloids and as Antagonist to Some Plant Fungal Pathogens. Microorganisms. 2022; 10(10):2089. https://doi.org/10.3390/microorganisms10102089
Chicago/Turabian StyleMunakata, Yuka, Rosella Spina, Sophie Slezack-Deschaumes, Julie Genestier, Alain Hehn, and Dominique Laurain-Mattar. 2022. "Screening of Endophytic Bacteria of Leucojum aestivum ‘Gravety Giant’ as a Potential Source of Alkaloids and as Antagonist to Some Plant Fungal Pathogens" Microorganisms 10, no. 10: 2089. https://doi.org/10.3390/microorganisms10102089
APA StyleMunakata, Y., Spina, R., Slezack-Deschaumes, S., Genestier, J., Hehn, A., & Laurain-Mattar, D. (2022). Screening of Endophytic Bacteria of Leucojum aestivum ‘Gravety Giant’ as a Potential Source of Alkaloids and as Antagonist to Some Plant Fungal Pathogens. Microorganisms, 10(10), 2089. https://doi.org/10.3390/microorganisms10102089







